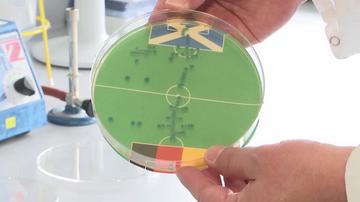
Bakterija E. coli zmago na uvodni tekmi EP-ja v nogometu napovedala Nemčiji

Škotskega navijača Craiga Fergusona so rojaki kot junaka sprejeli na slikovitem trgu Marienplatz. V zadnjih 41 dneh je namreč prehodil približno 1600 kilometrov – iz Glasgowa se je odpravil na odisejado do Münchna. S popotovanjem je zbiral denar za dobrodelne ustanove, ki se posvečajo duševnemu zdravju moških. Na stotine škotskih navijačev njegov prihod na trg pospremilo z vzklikanjem in petjem, poškropili so ga tudi s pivom.
"Lagal bi, če bi rekel, da to ni bila najtežja stvar, kar sem jih kdaj naredil," je dejal Ferguson, ki je bil izčrpan, a vzhičen. "Izkoristil sem adrenalin in motivacijo zavedanja, da sem že skoraj na cilju," je pojasnil, od kod mu energija, da podvig uspešno izpelje.
"Ničesar ne bi spremenil. Vsak trenutek te poti, tako dober kot slab, me je pripeljal sem," je povedal Škot in dodal, da so v dobrodelne namene zbrali več kot 60.000 funtov (okoli 71.400 evrov).

Evropsko prvenstvo v Nemčiji bo danes odprla tekma med gostitelji, ki so veliki favoriti, in Škoti. Izid uvodnega soočenja je napovedalo več živih bitij. Z nedavno napovedjo bakterije E. coli, ki je razglasila, da bo tekmo dobila Nemčija, se strinjata tudi "živalska preroka" orangutan Walter in slonica Bubi.
Walter izbral vedro, Bubi pa brcnila žogo
35-letni Walterju, ki živi v živalskem vrtu v Dortmundu, prerokovanje izidov tekem ni tuje – že večkrat je delil svoje napovedi za različna nogometna prvenstva in tekmovanja. V ogrado so mu dan pred uvodno tekmo postavili dve vedri, eno z nemškim šalom, drugo s šalom Škotske.
"Walter se je ustavil pred vedroma, si ogledal oba in se odločeno odpravil proti nemškemu vedru," je proces opisal tiskovni predstavnik živalskega vrta Marcel Stawinoga in pristavil, da je sreča po njegovi razlagi tako na strani Nemčije. Dodal pa je, da je nato orangutan vseeno šel tudi k škotskemu vedru. "Morda bodo Škoti zelo blizu," je pristavil, poroča Reuters.

Svoj uvid v to, kako kaže državi gostiteljici, je razkrila tudi samica afriškega slona, ki živi v rezervatu v Turingiji v osrednji Nemčiji. Bubi, ki je doma iz Italije, je morala brcniti žogo proti zastavam Nemčije in Škotske, ki sta bili na obeh straneh improviziranih vrat. Žoga se je skotalila proti nemški zastavi, ki jo je slonica nato ponosno zavihtela, poroča AP.
Za enega najbolj znanih "orakljev" še vedno velja hobotnica Paul, ki je živela v akvariju v nemškem mestu Oberhausen. Zaslovela je na svetovnem prvenstvu leta 2010 zaradi svoje neverjetne sposobnosti napovedovanja izidov tekem Nemčije – pravilno je napovedala, kako bo igrala na sedmih tekmah.

Komentarji so trenutno privzeto izklopljeni. V nastavitvah si jih lahko omogočite. Za prikaz možnosti nastavitev kliknite na ikono vašega profila v zgornjem desnem kotu zaslona.
Prikaži komentarje